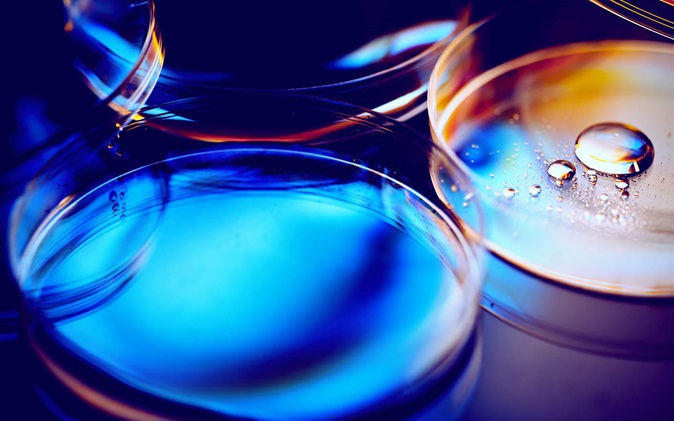

BStartup Health, el programa dedicado a startups de salud de Banco Sabadell, ha invertido 100.000 euros en la startup Gate2Brain. Esta es su segunda inversión entre las startups seleccionadas en la tercera convocatoria del programa.
Con la inversión de BStartup la compañía alcanza una inversión de 600.000 euros. La financiación general está liderada por la inversión previa realizada por Mind the Gap, el programa de impulso al emprendimiento biotecnológico de la Fundación Botín. Las Instituciones recibieron financiación de la Agencia de Gestión y Ayudas Universitarias y de Investigación (AGAUR) y de CaixaImpulse para desarrollar el proyecto.
Gate2Brain es empresa creada por investigadores del IRB Barcelona, la Universidad de Barcelona (UB) y el Instituto de Investigación de Sant Joan de Déu – Hospital Sant Joan de Déu (SJD), que ha desarrollado una novedosa tecnología para transportar fármacos al cerebro.
Gate2Brain combina varias familias de péptidos para franquear la barrera hematoencefálica, que dificulta el acceso de la mayoría de los fármacos al cerebro y que hace extremadamente complejo llegar a este órgano. La industria farmacéutica ha invertido millones de euros en el desarrollo de fármacos para el sistema nervioso central. El 98% de ellos no atraviesan la barrera hematoencefálica y resultan fallidos.
Como explica Meritxell Teixidó, CEO de la compañía: “La inversión de BStartup nos permitirá explorar cómo nuestra tecnología, que cruza barreras biológicas puede ahora mejorar el transporte de fármacos al cerebro para luchar contra tumores pediátricos”.
Marta Campillo, analista de inversiones de BStartup, ha valorado la inversión en Gate2Brain: “Creemos que Gate2Brain es una empresa que puede jugar un gran papel en el tratamiento de enfermedades cerebrales y estamos muy satisfechos de apostar por una spin off que sale del ámbito universitario con un equipo de buenísimos investigadores”
TERCERA CONVOCATORIA DE BSTARTUP HEALTH
Gate2Brain es la segunda inversión formalizada de las cuatro startups seleccionadas dentro de la tercera convocatoria BStartup Health. Dicho programa apota a proyectos de salud en fases pre-seed y seed. La inversión va dirigida fundamentalmente a validar la tecnología, la investigación y el negocio.
Cada uno de ellos recibirá una inversión de 100.000 euros y se beneficiará de un programa de acompañamiento. En él recibirán mentorización por parte de uno de los cuatro integrantes del prestigioso comité científico-técnico de BStartup Health. Estos son, la Dra. Clara Campàs, cofundadora de Asabys Partners; Carlos Gallardo, fundador de CG Health Partners y miembro del consejo de administración de Almirall; el doctor Damià Tormo, fundador y general partner de Columbus Venture Partners; y la doctora Montserrat Vendrell, partner en Alta Life Sciences.
Este mentoring consistirá en un asesoramiento de negocio a nivel estratégico, la definición de la hoja de ruta y el asesoramiento en la estrategia de fundraising, entre otros.